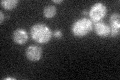
YDR084C
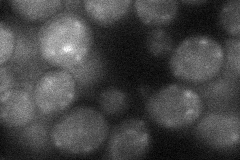
YDR084C
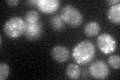
YDR084C
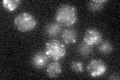
YDR084C

View description
Integral membrane protein localized to late Golgi vesicles along with the v-SNARE Tlg2p; green fluorescent protein (GFP)-fusion protein localizes to the cytoplasm in a punctate pattern
Localization:
Intensity:
Fold change:
Significance:
-
C’ GFP library in SD
punctate25.69 -
N' NOP1pr-GFP in SD

punctate94.9761 -
N' TEF2pr-mCherry in SD

vacuole195.416 -
N' NATIVEpr-GFP in SD

punctate,nucleus22.852 -
N' TEF2pr-VC and Cyto-VN in SD
punctate31.1215 -
C’ GFP library in SD+DTT
punctate23.350.9No -
C’ GFP library in SD+H2O2

punctate20.070.78No -
C’ GFP library in Starvation Media
punctate32.11.24No -
C’ GFP library on the background of Pup2-DaMP

punctate -
C’ GFP library on the background of CCT mutant

punctate19.2250.747989No
